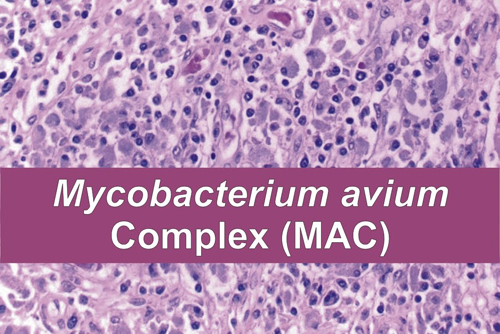

O bacterie care se găsește în lapte și-n carnea de vită este legată de apariția artritei reumatoide. Ce s-a descoperit mai exact?
O bacterie frecvent întâlnită în lapte și-n carnea de vită poate fi un declanșator al artritei reumatoide la persoanele care sunt expuse riscului genetic, potrivit unui nou studiu de la Universitatea din Florida. O echipă de cercetători de la Colegiul de Medicină UCF a descoperit o legătură între artrita reumatoidă și Mycobacterium avium, cunoscut sub numele de MAP, o bacterie găsită în aproximativ jumătate din vacile din Statele Unite. Bacteriile pot fi răspândite la oameni prin consumul de lapte infectat, carne de vită și produse fertilizate cu ajutorul gunoiului de vacă.
„Aici avem două boli inflamatorii: una afectează intestinul iar a doua articulaţiile. Au un factor comun care le declanşează? Aceasta a fost întrebarea la care am încercat să găsim un răspuns”, a precizat Saleh Naser, cercetător în cadrul studiului.
Pentru acest studiu, cercetătorii au recrutat 100 de pacienți care au oferit voluntar probe clinice pentru testare, toți suferind de poliartrită reumatoidă, toți având predispoziție genetică pentru a dezvolta o asemenea boală. În cazul a 78 de pacienți s-a găsit o mutație a genei PTPN2/22, aceeaşi mutaţie genetică găsită la pacienţii cu boala Crohn, iar 40% dintre aceştia aveau şi bacteria MAP.
„Noi credem că persoanele născute cu această mutație genetică şi care sunt expuse la MAP prin consumul laptelui contaminat sau a cărnii de la vitele infectate au un risc mai mare de a dezvolta artrita reumatoidă”, a concis Naser.
Numai în SUA, peste 1,3 milioane de adulți au artrită reumatoidă, o boală autoimună și inflamatorie care determină atacul sistemului imunitar asupra articulațiilor, mușchilor, oaselor și organelor. Pacienții suferă de dureri și deformări, mai ales la nivelul mâinilor și picioarelor. Boala poate să apară la orice vârstă, dar cel mai frecvent debut este între 40 și 60 de ani, fiind de trei ori mai răspândită în rândul femeilor.
Citiți și:
Dr. Rareș Simu, medic specialist în imunologie «Vaccinarea are apoi efecte nefaste chiar si asupra unui sistem imunitar sănătos»
HATHA YOGA ne învaţă arta de a fi sănătoşi (II)
Calea către o sănătate perfectă: echilibrul între acid și alcalin
yogaesoteric
31 mai 2018